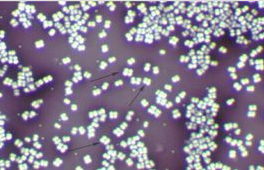
四聯球菌

四聯球菌

四聯球菌,(拉丁名:Micrococcus tetragenus),為微球菌科、四聯球菌屬。廣泛存在於人和動物的皮膚上,也廣泛分布於土壤、水、植物和食品上,是重要的食品腐敗性細菌。
基本信息
- 中文名:四聯球菌
- 域:細菌域 Bacteria
- 門:放線菌門 Actinobacteria
- 綱:放線菌綱 Actinobacteria
- 目:放線菌目 Actinobacterales
- 屬:四聯球菌屬
- 種:四聯球菌
形態特徵
大多數球菌直徑約0.5~2微米.沿兩個垂直的平面分裂,分裂後每四個細胞在一起呈田字形,稱四聯球菌。如
四聯微球菌Micrococcustetragenus。該菌菌落常表現為濕潤,粘稠,光滑,較透明,易挑取,質地均勻以及菌落正反面或邊緣與中央部位顏色一致等。 生態習性
好氧、不運動、氧化酶和過氧化氫酶陽性的球菌。細胞壁中不含磷壁酸,DNA的G+C克分子%含量為65%~75%。 四聯球菌對乾燥和高滲有較強抵抗力,可在5%NaCl環境中生長,最適生長溫度為25~37℃。不含DAP,無特徵性糖。接觸酶陽性,氧化酶陽性,v-p反應陰性,吲哚反應陰性,硝酸鹽還原陽性。
四聯球菌對乾燥和高滲有較強抵抗力,可在5%NaCl環境中生長,最適生長溫度為25~37℃。不含DAP,無特徵性糖。接觸酶陽性,氧化酶陽性,v-p反應陰性,吲哚反應陰性,硝酸鹽還原陽性。 經濟用途
廣泛存在於人和動物的皮膚上,也廣泛分布於土壤、水、植物和食品上,是重要的食品腐敗性細菌。在新鮮食品、加工食品和腐敗的食品中,該菌的檢出率都很高。對醬油風味起主要作用的細菌是嗜鹽足球菌和四聯球菌。四聯球菌能耐20%的食鹽,在發酵後期能生成一定量的乳酸。四聯球菌可引起肉類、魚類、水產製品、大豆製品等食品的腐敗。還引起皮膚感染的細菌。葡萄球菌屬易與微球菌屬混淆,葡萄球菌屬葡萄糖O/F試驗為發酵型,鏡下以葡萄狀排列為主,菌體較小;而微球菌屬為氧化型或無反應,鏡下以四聯排列為主,並且菌體較大。
 四聯球菌
四聯球菌
四聯球菌
四聯球菌